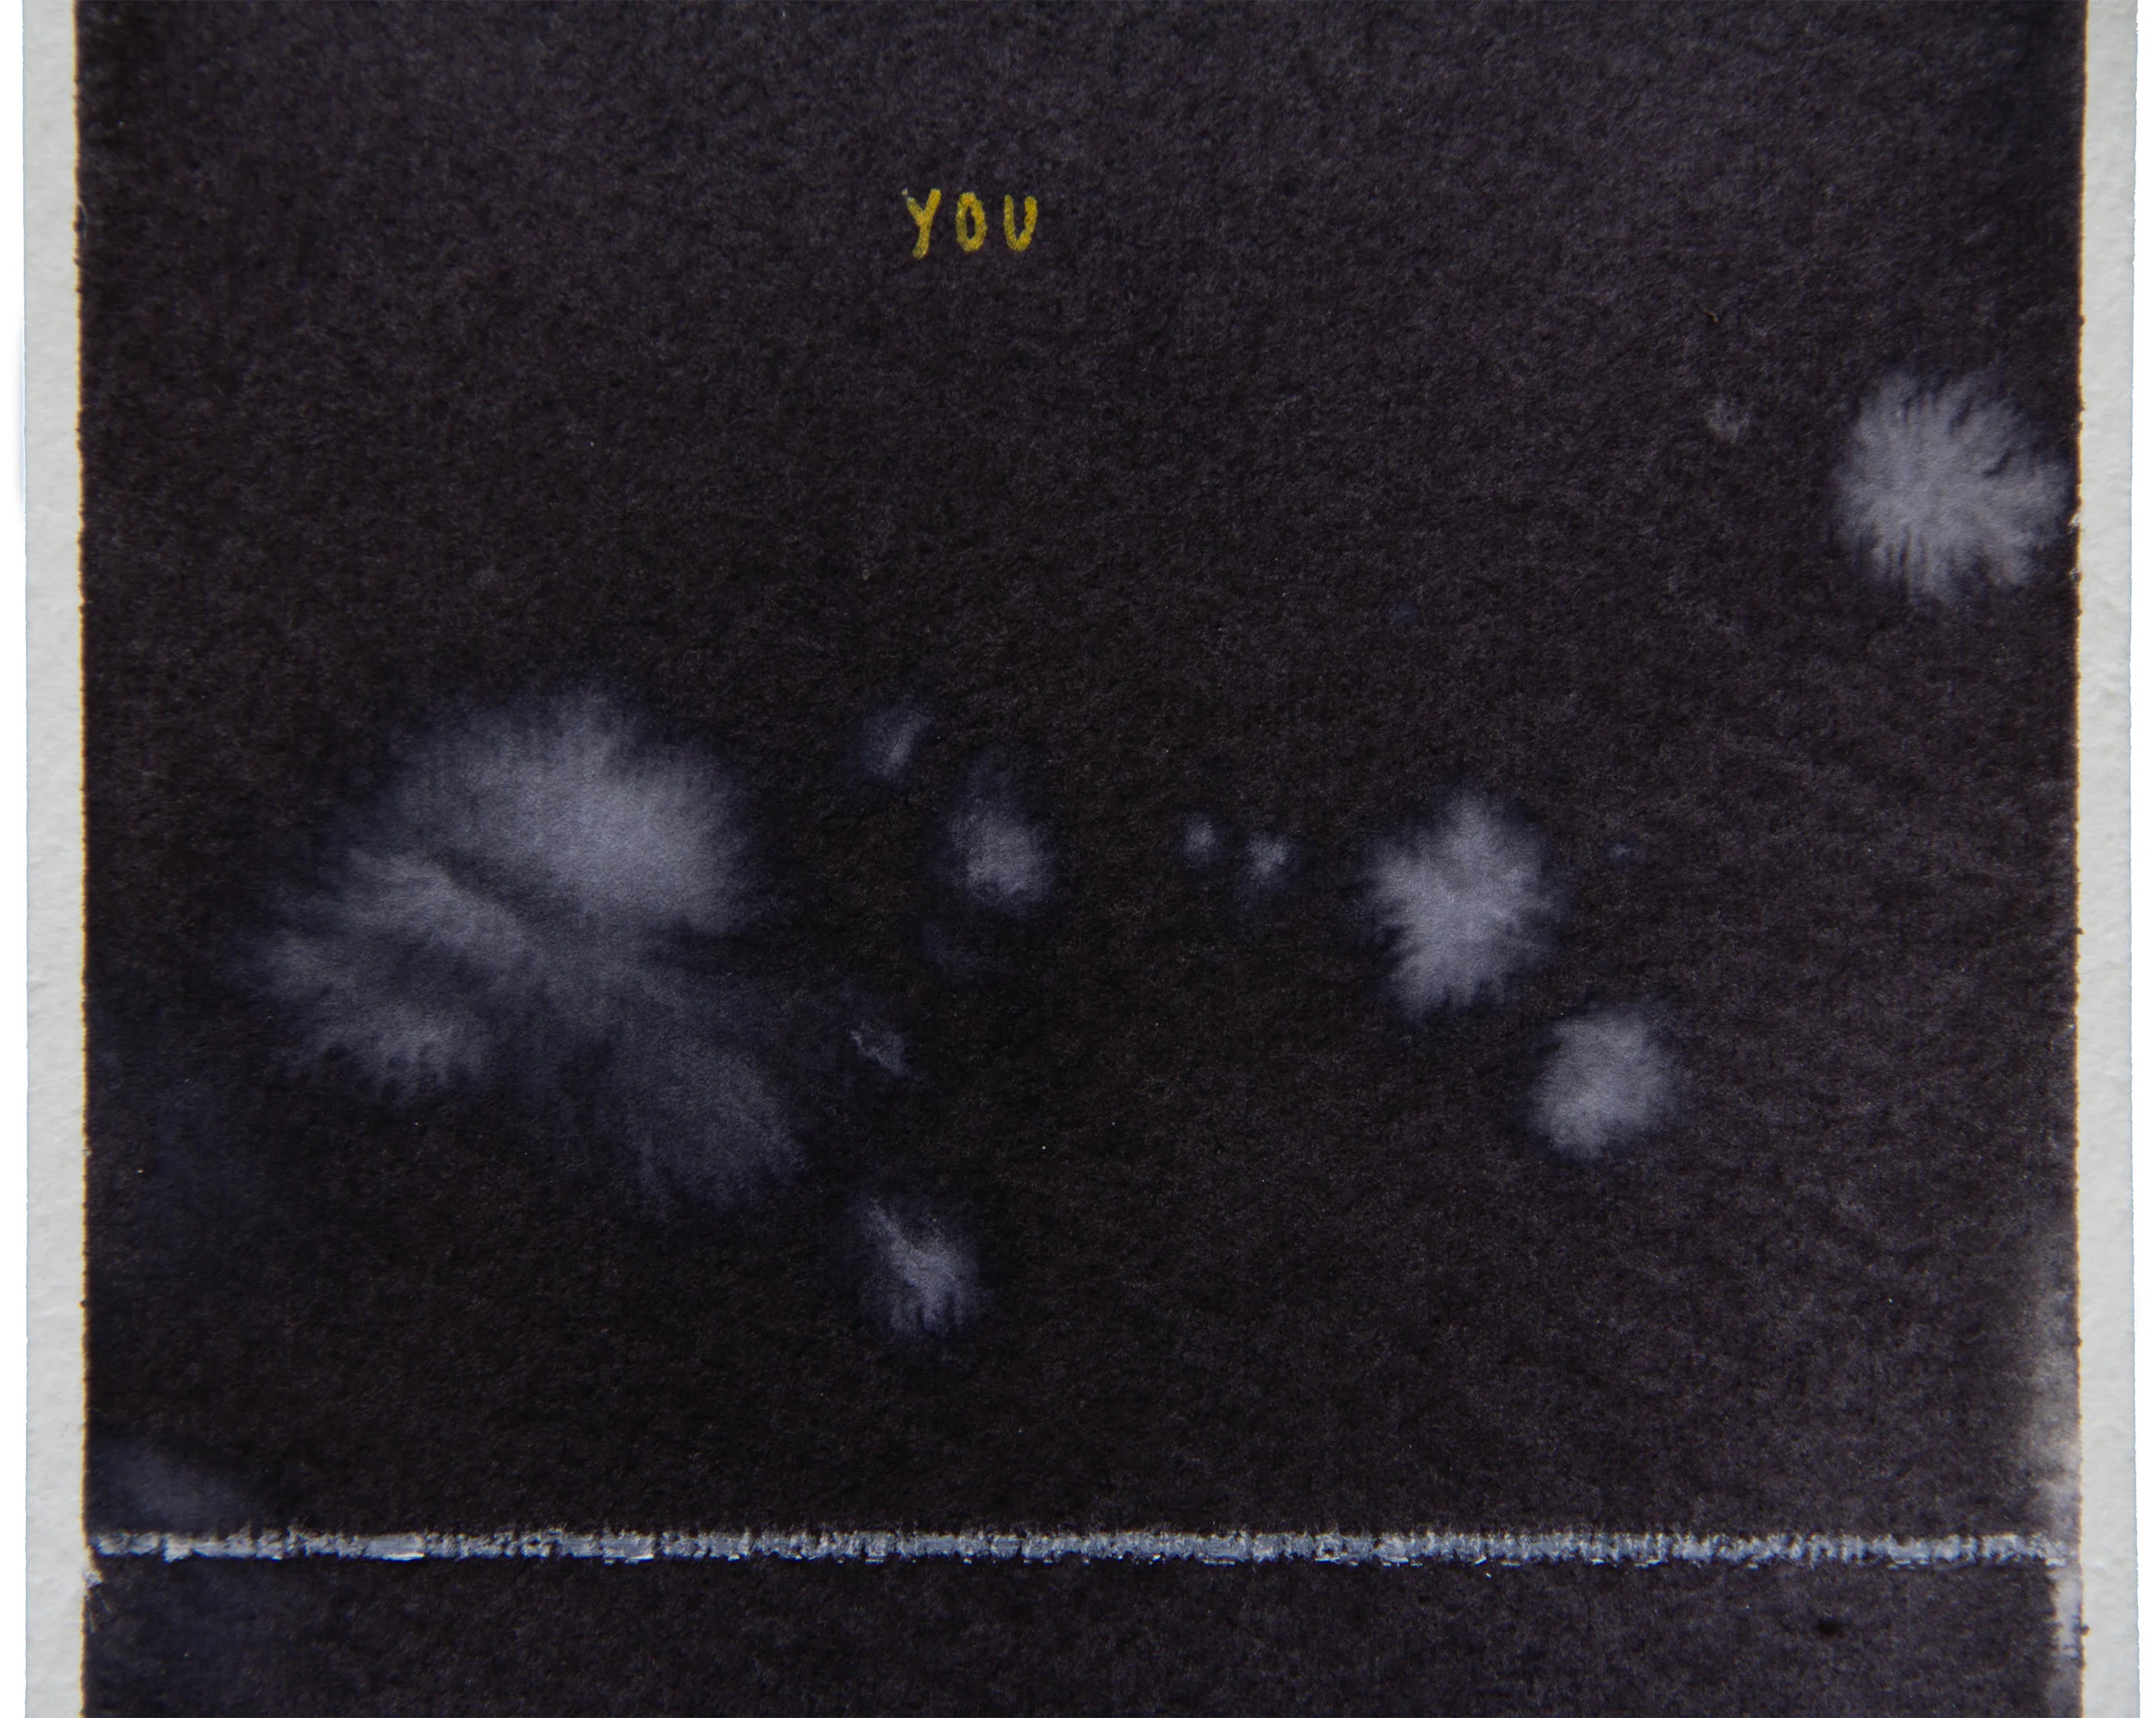

give it time (+Space)
ZEPPELIN STATION, DENVER, CO | JULY 2019
Notes:
This work takes place within an invented cosmic landscape
Though referential to biology and astronomy, none of these objects are of real scientific importance or have scientific accuracy
Love, space, and our natural world are connected